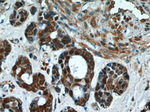
Thioredoxin Antibody in Immunohistochemistry (Paraffin) (IHC (P))

Search
Proteintech
Thioredoxin Polyclonal Antibody
{{$productOrderCtrl.translations['antibody.pdp.commerceCard.promotion.promotions']}}
{{$productOrderCtrl.translations['antibody.pdp.commerceCard.promotion.viewpromo']}}
{{$productOrderCtrl.translations['antibody.pdp.commerceCard.promotion.promocode']}}: {{promo.promoCode}} {{promo.promoTitle}} {{promo.promoDescription}}. {{$productOrderCtrl.translations['antibody.pdp.commerceCard.promotion.learnmore']}}
产品信息
14999-1-AP
种属反应
已发表种属
宿主/亚型
分类
类型
抗原
偶联物
形式
浓度
规格
纯化类型
保存液
内含物
保存条件
运输条件
产品详细信息
Immunogen sequence: MVKQIESKT AFQEALDAAG DKLVVVDFSA TWCGPCKMIK PFFHSLSEKY SNVIFLEVDV DDCQDVASEC EVKCMPTFQF FKKGQKVGEF SGANKEKLEA TINELV (1-105 aa encoded by B C003377)
靶标信息
Thioredoxins (Trx) are small, multi-functional proteins with oxidoreductase activity and are ubiquitous in essentially all living cells. Trx contains a redox-active disulfide/dithiol group within the conserved Cys-Gly-Pro-Cys active site. The two cysteine residues in the conserved active centers can be oxidized to form intramolecular disulfide bonds. Reduction of the active site disulfide in oxidized Trx is catalyzed by Trx reductase with NADPH as the electron donor. The reduced Trx is a hydrogen donor for ribonucleotide reductase, the essential enzyme for DNA synthesis, and a potent general protein disulfide reductase with numerous functions in growth and redox regulations. Specific protein disulfide targets for reduction by Trx include protein disulfide-isomerase (PDI) and a number of transcription factors such as p53, NF-kB and AP-1 (T1-151). Trx is also capable of removing H2O2, particularly when it is coupled with either methionine sulfoxide reductase or several isoforms of peroxiredoxins.
仅用于科研。不用于诊断过程。未经明确授权不得转售。
生物信息学
蛋白别名: ADF; ATL-derived factor; DKFZp686B1993; MGC61975; oxidoreductase; RP11-427L11.1; SASP; Surface-associated sulphydryl protein; testicular tissue protein Li 199; Thioredoxin; thioredoxin delta 3; Trx; TRX1; TXN; TXN delta 3; unnamed protein product
基因别名: TRDX; TRX; TRX1; Trx80; TXN; TXN1
UniProt ID: (Human) P10599
Entrez Gene ID: (Human) 7295